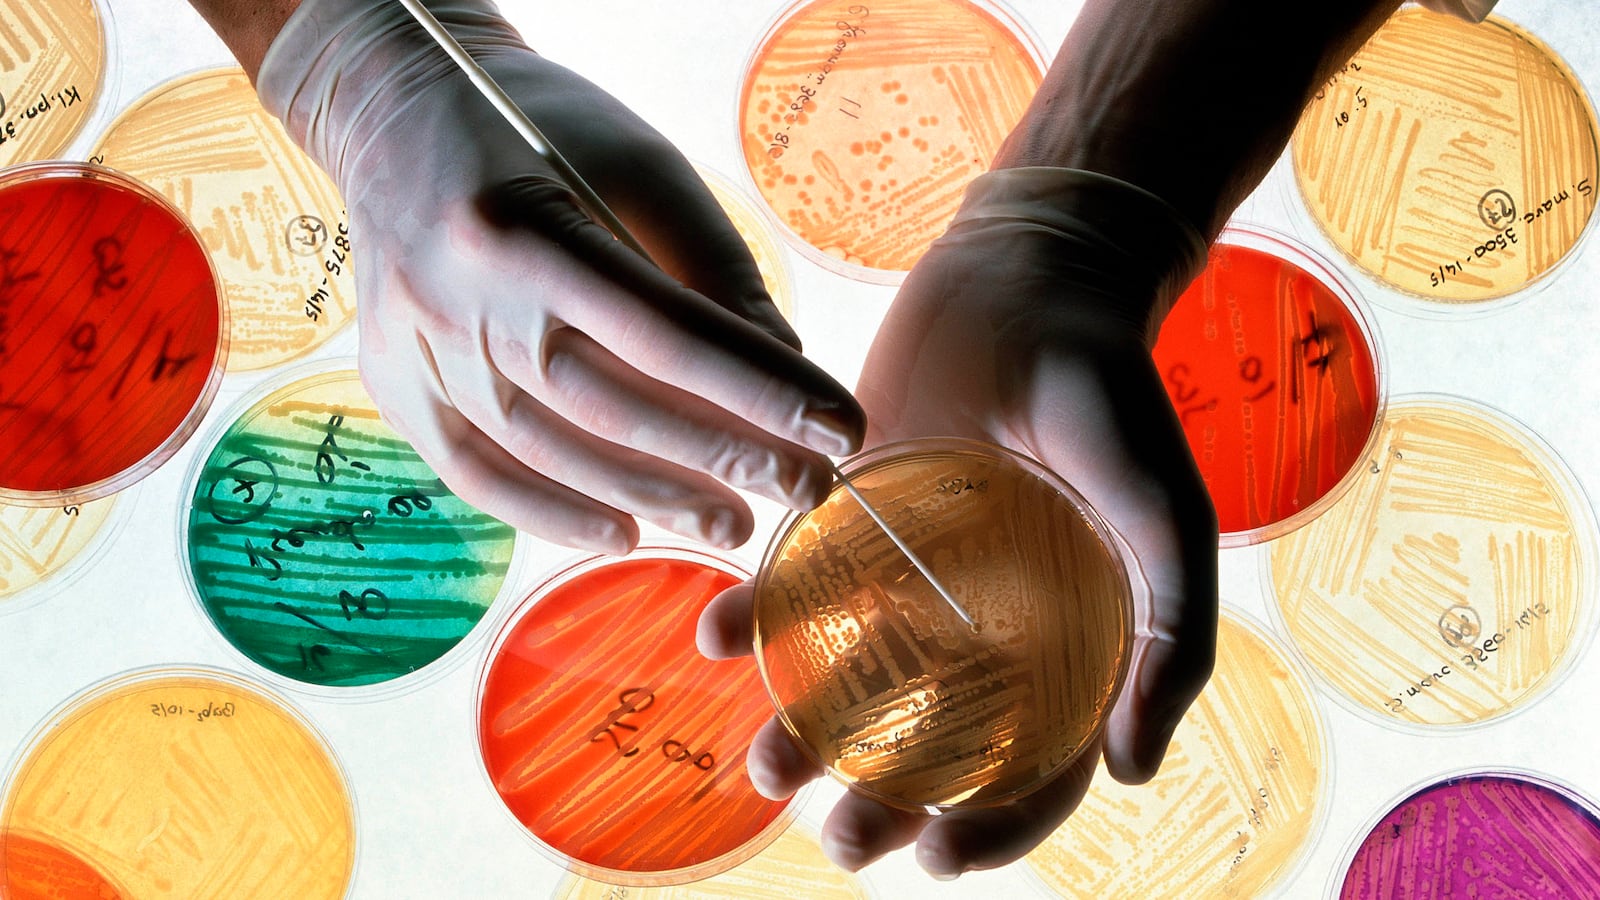
181219-conversation-genetic-bacteria-tease_dlgcti

By Pedro Belda Ferre, Postdoctoral Scholar in Pediatrics, University of California San Diego
A pill containing millions of bacteria ready to colonize your gut might be a nightmare to many. But it may become an effective new tool for fighting disease.
In many inherited genetic diseases a mutated gene means that an individual cannot make a vital substance necessary for their body to grow, develop or function. Sometimes this can be fixed with a synthetic substitute — a pill — that they can take daily to replace what their body should have made naturally. People with a rare genetic disease called phenylketonuria (PKU), lack an enzyme that is essential for breaking down protein. Without it, toxic chemicals build up in the blood and can cause permanent brain damage.
Fortunately, the fix is easy. Physicians treat the disease by putting their patients on a super low-protein diet for the rest of their life. Indeed, because the fix was so simple PKU was the first disorder for which newborn babies were routinely screened, beginning in 1961, by analyzing a drop of blood collected from a prick on the baby’s heel.
But imagine how challenging it can be to measure everything you eat during your entire life. To cure PKU researchers are currently exploring new treatment strategies. One involves using gene-editing tools to correct genetic mutations. However, the current technology is still risky; there is a chance of disrupting other genes and causing collateral damage to patients.
What if one could replace the broken gene without affecting the patient’s genome? That’s exactly what researchers at the Cambridge, Massachusetts-based biotech company Synlogic have done. They decided that rather than meddling directly with the human genome, they would introduce the therapeutic genes directly into the naturally occurring bacteria that reside in the human gut. These genetically modified bacteria would then produce the enzymes that PKU patients lacked and break down the proteins into non-toxic products.
I am a postdoctoral researcher at UCSD who studies the community of microbes that live within our bodies, and how they impact our health. Now we are starting to understand the role they play maintaining us healthy. The next step is figuring out how we can alter them to improve our health. And Synlogic’s study is bringing that dream a step closer.
Engineering bacteria living in our gut
You may be surprised to learn that our intestines are inhabited by trillions of bacteria that help us digest food, produce vitamins for us and educate our immune system. This community of microbes is our microbiome. Together they harbor millions of different genes in their genomes, outnumbering our human genes 150 to 1, and we can use them to our own benefit.
Escherichia coli Nissle 1917 is one of those microbes living inside most of us and has been widely used as a probiotic for over a century, proving its safety.
This is the bacterium that Synlogic chose to engineer to create a new therapeutic “super bacteria” called SYNB1618 for PKU patients.
The researchers introduced three genes that enable SYNB1618 to transform one of the building blocks of protein, an amino acid called phenylalanine, into the safe compound, phenylpyruvate. As long as the levels of phenylalanine are kept low, PKU patients don’t show any symptoms and live normal lives.
Are GM bacteria safe?
Opponents of genetically modified organisms might object to adding designer microbes into our guts. But just as they do with genetically modified foods, there are strict FDA regulations that ensure that these microbes are safe.
In the case of SYNB1618 the researchers deleted a gene responsible for producing an essential ingredient for building the bacteria. If the researchers don’t provide the missing ingredient for the engineered bacteria, they can’t replicate and will die. It’s a way for researchers to control the SYNB1618 in a patient’s body.
When they tested the microbes in mice they discovered that after 48 hours without the crucial ingredient, the SYNB1618 had vanished from their guts.
The researchers at Synlogic also took other precautions when engineering SYNB1618 and choosing which microbes to use for therapy. Other than the genes added to process phenylalanine, the engineered bacteria contains exactly the same genes as the original E. coli Nissle 1917 that is native to the gut, ensuring its safety.
Does it really work?
Once the researchers proved that the bacteria could convert the phenylalanine in the lab, they decided to administer the bacteria to mice with PKU. The results showed that SYNB1618 degraded phenylalanine circulating in the animals’ intestine, which lowered the levels in the blood of the treated mice.
Then, preparing for tests in humans, researchers tested the SYNB1618 on monkeys, to ensure safety and efficacy in humans. Healthy monkeys without PKU were fed phenylalanine and given a dose of the microbes afterwards. The SYNB1618 bacteria successfully reduced the phenylalanine blood levels - just as they did in the mouse.
Synlogic is currently testing SYNB1618 in humans in a phase 1 clinical trial.
This is a step toward a new therapeutic approach that offers great potential to treat human diseases like diabetes and cancer and to monitor inflammation levels in inflammatory bowel diseases.
As we discover and understand the role of all the microbes that inhabit our bodies I expect that we will identify microbes that may be the perfect vehicles for carrying various gene therapies that treat even more diseases, including those involving metabolism and the central nervous system.